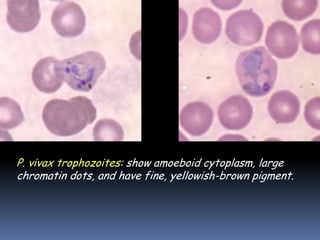
P. vivax trophozoites: show amoeboid cytoplasm, large
chromatin dots, and have fine, yellowish-brown pigment.

This document summarizes various microbial diseases that can affect the cardiovascular and lymphatic systems. It discusses topics like sepsis, bacterial infections of the heart, rheumatic fever, tularemia, brucellosis, anthrax, biological weapons, gangrene, animal bites and scratches, plague, relapsing fever, Lyme disease, ehrlichiosis, typhus, spotted fevers, viral infections caused by herpes viruses and cytomegalovirus, viral hemorrhagic fevers, Chagas disease, toxoplasmosis, malaria, and other protozoan infections. Diagrams are provided to illustrate concepts like the tick life cycle, stages of malaria infection, and Plasmodium fal